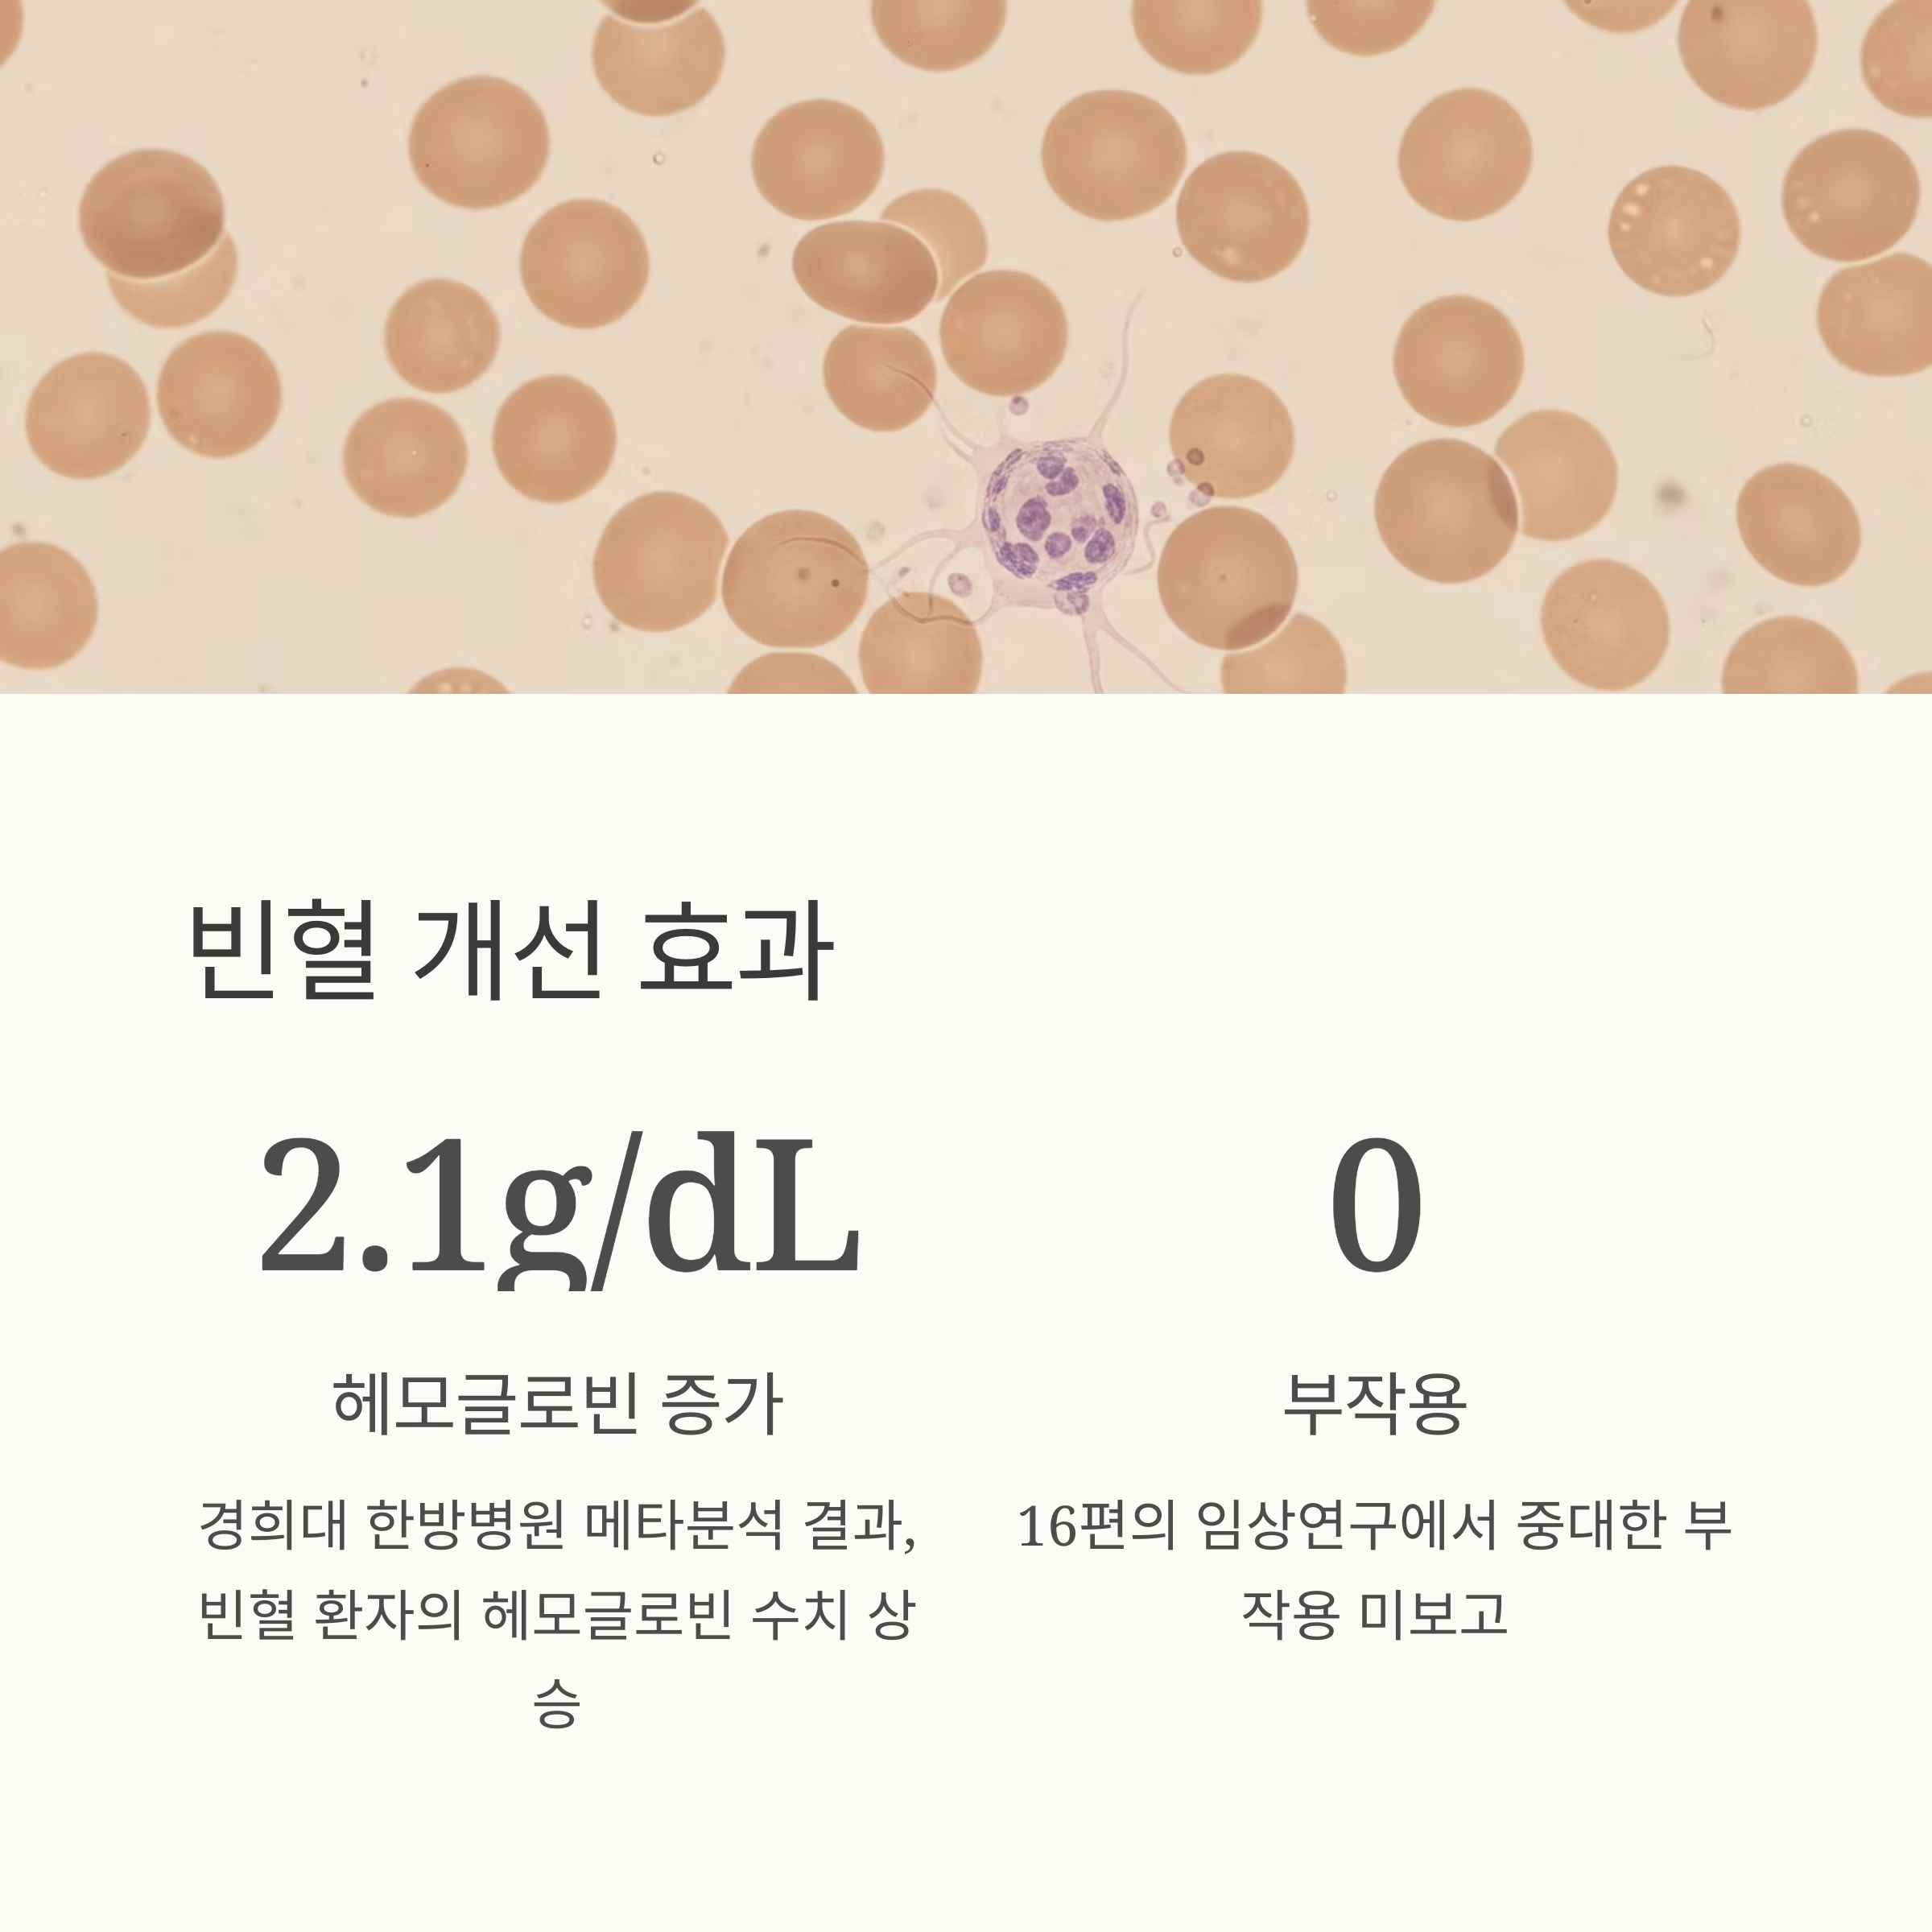
빈혈 개선 효과

빈혈 개선부터 피로 회복까지, 십전대보탕의 임상적 효과는?

십전대보탕은 인체의 기와 혈을 동시에 보충해주는 대표적인 한방 보약으로, 병후 회복기나 만성 피로, 면역 저하에 효과가 있다고 알려져 있습니다. 최근에는 다양한 임상연구와 실험 논문을 통해 십전대보탕의 과학적 효능이 입증되면서 다시 주목받고 있습니다. 특히 빈혈 개선, 피로 완화, 면역력 증진에 대한 구체적인 데이터가 공개되며, 실제 활용도가 높아지고 있습니다. 이 글에서는 십전대보탕의 효능과 작용 기전, 안전성까지 전반적인 내용을 정리해드립니다.

십전대보탕이란 무엇인가요?
십전대보탕은 총 10가지 한약재로 구성된 전통적인 보약입니다.
인삼, 황기, 숙지황, 당귀, 백출, 백복령, 감초, 백작약, 천궁, 육계가 그 재료이며
기혈을 보강하고 몸의 회복력을 높이기 위해 오래전부터 사용돼 왔습니다.
특히 한방 고전인 동의보감에서도 기혈허약, 병후 쇠약, 피로권태, 식욕부진,
손발 차가움, 허약 체질 등에 유용한 약재 조합으로 기록돼 있습니다.
연구로 검증된 빈혈 개선 효과
경희대 한방병원의 2024년 메타분석에 따르면, 십전대보탕은 다양한
빈혈 환자에게서 헤모글로빈 수치를 유의하게 증가시킨 것으로 나타났습니다.
수술 후 빈혈, 위장관 출혈, 만성 신장질환, 골수이형성증후군 환자들에게
복용 전후 헤모글로빈 수치가 평균 1.2~2.1g/dL 증가하였고,
부작용은 임상연구 16편 중 단 한 건도 보고되지 않았습니다.
연구 항목 주요 결과
| 대상 환자군 | 수술 후 빈혈, 만성질환성 빈혈 포함 |
| 헤모글로빈 수치 | 평균 1.2~2.1g/dL 증가 |
| 부작용 | 없음(중대한 이상반응 미보고) |

암환자 대상 피로 회복 임상시험
한 무작위 대조 임상시험에서는 암 치료 중 피로를 겪는 환자 60명을 대상으로
3주간 십전대보탕을 복용하게 한 결과, 피로 점수가 33.9% 감소했습니다.
복용 전 6.2점이었던 피로 점수는 복용 후 4.1점으로 크게 낮아졌으며,
6주 후에도 효과는 지속되었습니다.
삶의 질(QoL) 점수도 복용군에서 12.5% 향상되었으며, 대조군은 2.1%에 그쳤습니다.
이는 단순 기분 개선이 아닌 생리적 원기회복 작용을 의미합니다.

소아 면역력 증진 사례에서도 유의한 효과
반복적인 중이염으로 고통받는 소아 70명을 대상으로 한 연구에서는
십전대보탕 복용군에서 월평균 중이염 발생 횟수가 43% 감소하였습니다.
복용 첫 달에는 평균 0.81회, 셋째 달에는 0.39회까지 떨어졌으며
복용하지 않은 대조군에서는 뚜렷한 감소 경향이 나타나지 않았습니다.
이는 십전대보탕의 면역력 증진 효과가 실제 임상에서 유효함을 보여줍니다.

작용 기전은 어떻게 설명되나요?
십전대보탕은 단순한 에너지 보충을 넘어, 조혈과 면역 시스템 전반을
활성화시키는 기전을 갖고 있습니다.
주요 작용 기전은 다음과 같습니다.
- 골수 내 적혈구 생성 촉진 (에리스로포이에틴 증가)
- 대식세포와 비장세포의 활성을 통한 면역 증진
- 항산화 작용으로 뇌혈류 및 신경계 기능 보완
- 위장관 흡수 기능 개선으로 영양 흡수율 상승
주요 작용 부위 기능 설명 대표 성분
| 골수 | 적혈구 생성 촉진 | 숙지황, 황기 |
| 소화기관 | 소화기능 강화 및 식욕 증진 | 백출, 감초 |
| 신경계 | 항산화 작용 및 혈류 개선 | 천궁, 인삼 |
| 면역계 | 대식세포, 비장세포 활성화로 면역력 증가 | 인삼, 황기, 당귀 |

안전성은 어떻게 검증되었나요?
안전성 역시 다양한 동물실험과 임상연구에서 입증되었습니다.
SD 랫드와 ICR 마우스를 대상으로 한 급성 독성 실험에서
LD50(치사량)이 5000mg/kg 이상으로 매우 안전한 수치가 확인되었고,
유전독성, 생식독성, 발암성 등에서도 유의미한 이상반응은 나타나지 않았습니다.
임상연구 16편에서도 중대한 부작용은 단 1건도 보고되지 않았으며,
장기 복용 사례에서도 안전성이 입증되었습니다.

실제 임상에서 활용되는 사례와 범위
십전대보탕은 현재 병후 회복기, 수술 후 체력저하, 만성 피로, 갱년기 체력저하,
빈혈 증상 완화, 반복성 감염 예방 등 다양한 상황에서 처방되고 있습니다.
특히 암환자, 노인, 산모, 학생 등 신체 회복력이 필요한 인구층에게
면역력 강화 및 기력 회복 목적으로 광범위하게 활용되고 있습니다.
이처럼 과학적 데이터와 임상 결과에 기반한 처방으로서
십전대보탕은 단순한 전통 보약을 넘어 현대 의학적 관점에서도
충분한 검증을 거친 한방 치료 옵션입니다.
'우리몸지키미' 카테고리의 다른 글
| 당수치 정상유지, 이 운동법이면 충분해요 (3) | 2025.07.12 |
|---|---|
| 치즈 vs 버터, 건강에 더 좋은 건? (1) | 2025.07.12 |
| 복부CT 검사 꼭 필요한 순간, 놓치면 큰일나요 (1) | 2025.07.11 |
| 편두통 심할 때 꼭 알아야 할 원인과 대처법 (3) | 2025.07.11 |
| 다래끼 초기에 잡는 꿀팁, 절대 놓치지 마세요 (0) | 2025.07.10 |